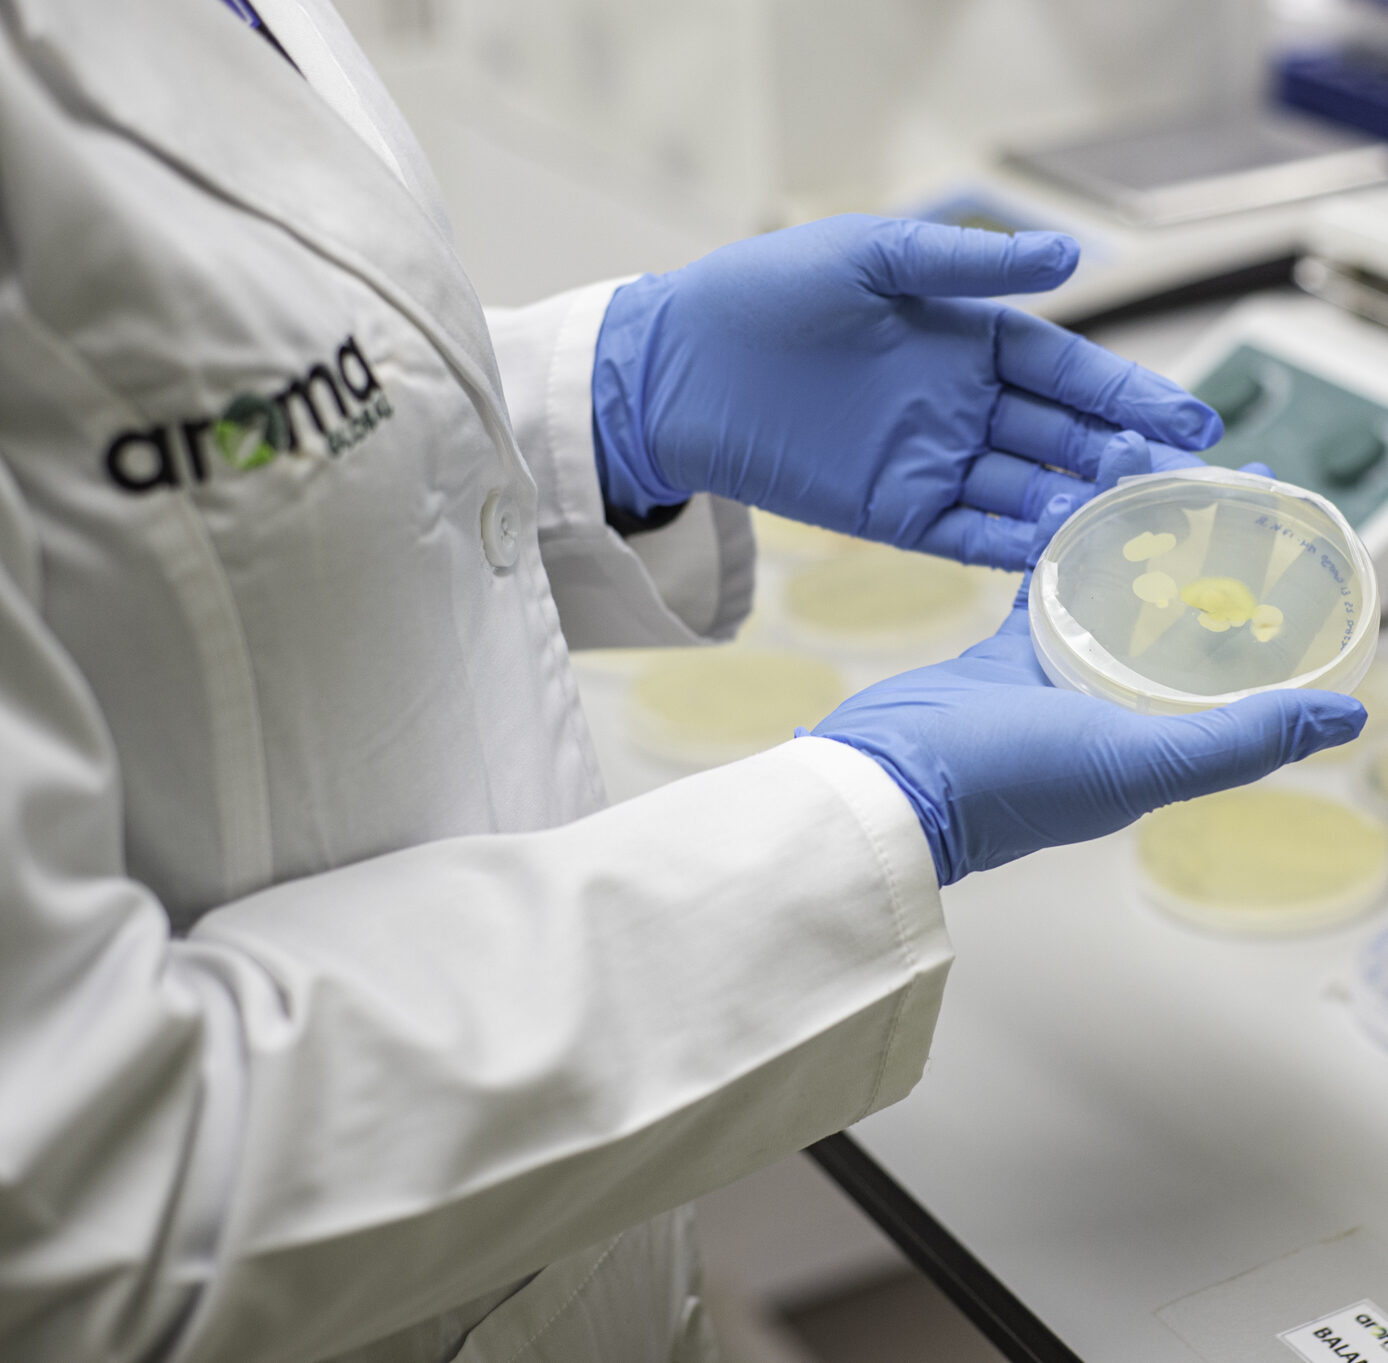

¡Hoy, en el Día Internacional de la Sanidad Vegetal, celebramos nuestro compromiso con la protección de las especies vegetales, un pilar fundamental para garantizar la seguridad alimentaria, fomentar la sostenibilidad agrícola y proteger nuestra biodiversidad y medio ambiente.
Desde Aroma Global®, liderados por la destacada fitopatóloga Dra. Ana Luisa Valencia, nos enorgullecemos de aportar significativamente a esta causa. A través de nuestras soluciones biotecnológicas, basadas en investigación científica y con los más altos estándares de calidad, contribuimos al desarrollo económico en el sector agrícola, asegurando que la productividad y calidad de los cultivos prevalezcan.
Invitamos a nuestra comunidad a reflexionar sobre la importancia de la sanidad vegetal y a visitar nuestro perfil para conocer más sobre cómo nuestras innovaciones agrícolas están marcando la diferencia.